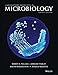
Laboratory Exercises in Microbiology
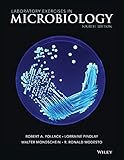
Laboratory Exercises in Microbiology

Gathering data for you
Our Price Comparison is FREE to use. You are moments away from:
- Buy, Rent or Sell
- New, Used, Rental, eBooks
- Finding the Cheapest Prices
- Saving up to 95%
Check outfacebook
our fan page on
for additional ways to save.
Search results for: ' Robert A. Pollack'
-
Laboratory Exercises in Microbiology
- Spiral-bound
- Edition:
- 4
- Publisher:
- Wiley
- Release Date:
- 2011
- ISBN-10:
- 1118135253
- ISBN-13:
- 9781118135259
- List Price:
- $134.95
-
Laboratory Exercises in Microbiology
- Spiral-bound
- Edition:
- 3
- Publisher:
- Wiley
- Release Date:
- 2008
- ISBN-10:
- 0470133929
- ISBN-13:
- 9780470133927
- List Price:
- $149.00
-
Lab Exercises in Microbiology 5e
- Paperback
- Publisher:
- Wiley
- Release Date:
- 2018
- ISBN-10:
- 1119465672
- ISBN-13:
- 9781119465676
-
Laboratory Excercises in Microbiology
- Paperback
- Edition:
- 2nd
- Publisher:
- John Wiley & Sons
- Release Date:
- 2005
- ISBN-10:
- 0471420824
- ISBN-13:
- 9780471420828
-
Seventy-Eight Degrees of Wisdom: A Tarot Journey to Self-Awareness (A New Edition of the Tarot Classic)
- Paperback
- Edition:
- Third Edition, Revised
- Publisher:
- Weiser Books
- Release Date:
- 2019
- ISBN-10:
- 1578636655
- ISBN-13:
- 9781578636655
- List Price:
- $22.95
-
The Pun Also Rises: How the Humble Pun Revolutionized Language, Changed History, and Made Wordplay More Than Some Antics
- Paperback
- Edition:
- Reprint
- Publisher:
- Avery
- Release Date:
- 2012
- ISBN-10:
- 1592406750
- ISBN-13:
- 9781592406753
- List Price:
- $16.00
-
Real Boys: Rescuing Our Sons from the Myths of Boyhood
- Paperback
- Edition:
- 1
- Publisher:
- Owl Books
- Release Date:
- 1999
- ISBN-10:
- 0805061835
- ISBN-13:
- 9780805061833
- List Price:
- $24.99
-
The New Tarot Handbook: Master the Meanings of the Cards
- Paperback
- Edition:
- Reprint
- Publisher:
- Llewellyn Publications
- Release Date:
- 2012
- ISBN-10:
- 0738731900
- ISBN-13:
- 9780738731902
- List Price:
- $15.95
-
Pothead: My Life as a Marijuana Addict in the Age of Legal Weed
- Paperback
- Publisher:
- Central Recovery Press
- Release Date:
- 2020
- ISBN-10:
- 1949481301
- ISBN-13:
- 9781949481303
- List Price:
- $18.95
-
Rachel Pollack's Tarot Wisdom: Spiritual Teachings and Deeper Meanings
- Paperback
- Edition:
- Illustrated
- Publisher:
- Llewellyn Publications
- Release Date:
- 2008
- ISBN-10:
- 0738713090
- ISBN-13:
- 9780738713090
- List Price:
- $26.99
© CheapestTextbooks.com 2001-2026. All rights reserved.